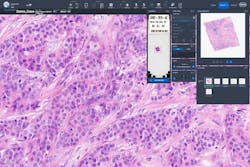
Figure 1: Scanned H&E image for primary diagnosis, or comparison with IHC and/or special stains. Figure 1: Scanned H&E image for primary diagnosis, or comparison with IHC and/or special stains.

To take the April CE test online go HERE. For more information, visit the Continuing Education tab.
LEARNING OBJECTIVES
Upon completion of this article, the reader will be able to:
1. Describe how digital pathology works in the laboratory to support patient care.
2. Describe typical applications of digital pathology.
3. Demonstrate an overall understanding of current technologies used in digital pathology.
4. Describe key considerations for implementing digital pathology.
Advancements in whole slide imaging (WSI), also known as digital pathology, now support the ability of clinical laboratories to image large numbers of slides rapidly and at high resolution.1 Entire stained tissue sections from glass slides can be viewed by a pathologist on a computer monitor, where digital images can be magnified and visualized in a way that feels like standard microscopy. Similar to the transition in radiology from film to digital images, pathology labs feel the pressure to develop more efficient digital workflows and reduce the time to diagnosis.2 Embracing digitization of slides has the potential to revolutionize the delivery of pathology services as labs face increasing volumes and complexity in the histopathology workload.3
Digital pathology today
Digital pathology is a dynamic, image-based environment that enables the acquisition, management, and interpretation of pathology information generated from a digitized glass slide.4 Common applications include primary diagnosis, review of immunohistochemistry (IHC) and/or special stains, intraoperative consultation, second opinion consultation, and presentation at a tumor board.2 To further clarify, primary diagnosis is the establishment of a final diagnosis solely by review of the hematoxylin and eosin (H&E) stain based on the histopathologic findings of the pathologist. In addition, slide digitization enables the use of artificial intelligence (AI) derived algorithms for clinical decision support, which is perhaps the most exciting and rapidly advancing technology to be deployed in pathology. Examples include H&E image analysis for cancer detection and classification, and quantitative image analysis for IHC biomarkers like HER2 and PD-L1. WSI and AI image analysis will likely become integral to the practice of pathology and are already helping pathologists to improve workflow and turnaround times, support accurate and timely diagnosis, and may ultimately contribute to improved patient care.5,6,7
Digital pathology ecosystem
The digital pathology ecosystem is composed of three main parts — information systems, whole slide imaging systems (which include scanners, image management software, and monitors), and system tools such as native applications, third party applications, and image analysis.
Many labs may be familiar with the whole slide scanner and the digital image viewer. To truly harness the power of digital pathology, a full ecosystem needs to be implemented where the whole slide system is integrated with one or more of following systems: hospital information systems (HIS), picture archiving and communication systems (PACS), laboratory information systems (LIS), electronic medical record (EMR), and/or radiology information systems (RIS).
Digital pathology begins with a whole slide image (WSI) scanner that captures an entire glass slide in high-resolution images comparable to images seen under brightfield microscopes. Scanners can accommodate a broad range of stain or specimen types, including H&E, IHC, in situ hybridization (ISH), special stains, cytology, and frozen sections. Historically, whole slide imaging systems store image data in proprietary file formats. While these systems allow interactive viewing, the proprietary nature of data formats and interfaces create vendor lock-in and impede data access.8 Other specialties, such as radiology, use Digital Imaging and Communications in Medicine (DICOM®) as the standard for the representation, storage, and communication of medical images and related information. While a DICOM file format for pathology has been defined, adoption by vendors is varied, limiting interoperability with other software solutions.8
Image quality, reliability, ease of use, and speed are all important considerations when choosing a whole slide imaging system. A tray-based system can reduce slide-handling errors, such as breakage, jams, and failure to pick up. Other considerations include capacity, with the flexibility to accommodate future growth of digital image interpretation, and built-in calibration to enhance accuracy.
Central to the digital pathology workflow is a dedicated software for pathologists, histologists, and administrators to view, organize, retrieve, and integrate digital images for a comprehensive review of disease status. Software systems that are intuitive, easy to use, and provide annotation tools can optimize user experience and workflow.
With the acceleration of personalized healthcare and increased test complexity, flexible software solutions that integrate third party vendor tools offer pathologists more choice and flexibility to adapt the digital workflow to their specific environment. For example, imagine how difficult it would be to operate a smartphone if an integrated app store did not include apps developed by third parties. This flexibility allows for faster innovation and improves access to the latest technologies with minimal disruption to the digital workflow.
Advantages of digital pathology
Compared with using glass slides and a microscope, digital pathology offers multiple advantages.
One operational benefit of WSI is the elimination of courier costs for transportation of physical glass slides to multiple locations.9 Instead of transporting slides to pathologists for diagnosis, slides are scanned at or near the point of collection. Scanning at or near the point of collection can reduce the risk of slides being lost, mislabeled, or damaged during physical transport, which impacts patient safety.3 Digitization also preserves the integrity and quality of the original slide by eliminating the risk of fading, stain degradation, or other changes to physical slides during storage or transport.3 Since whole slide images are delivered electronically, remote review is immediate and collaboration can take place across geographic regions, reducing time to results.9 Furthermore, a digital workflow may provide faster access to molecular and other ancillary testing.3
Digital pathology also enables a flexible and remote work environment that can increase recruitment and retention of pathologists, potentially prolonging careers of senior pathologists and providing a remote sign out option for locum tenens staff.3
Whole slide imaging can improve pathology service quality by streamlining access to archived images. For example, direct comparison of digital H&E and IHC images from a former tumor biopsy with a current resected tumor from the same patient, may reduce additional costly immunohistochemical testing.3 To review a previous biopsy in the current glass slide workflow, slides must be pulled from the archive, potentially couriered/transported to the pathologists, then returned and refiled in the archive, all of which is time consuming to the pathologist and the ancillary staff. Digital pathology software permits synchronous analysis of multiple slides on a single screen, permitting faster and easier review.3 Access to on screen measurements tools make cancer staging more convenient and potentially more accurate and reproducible, with a clear audit trail of who has viewed the images and made annotations.3 For immunohistochemical analysis of biomarkers like HER2 and PD-L1 with targeted therapies, interobserver variability in manual scoring may impact patient treatment.10,11 The addition of biomarker quantitative image analysis (QIA) to the digital workflow offers a reproducible and objective method to decrease interobserver variability, improve therapy selection, and potentially lead to better patient outcomes.11,12
Regulatory and reimbursement considerations
The COVID-19 pandemic facilitated adoption of digital pathology for remote use in two ways. First, the Food and Drug Administration (FDA) issued guidance in April 2020, for the duration of the COVID-19 public health emergency, that allowed the marketing of new digital pathology devices that are intended for use in remote settings and that are not currently 510(k) cleared for any use.14 This guidance document expired in November 2023.15 Secondly, the Centers for Medicare & Medicaid Services (CMS) provide an updated memorandum in May 2023 pertaining to the continued use of remote digital image viewing: “To ensure the accuracy, reliability and timeliness of laboratory results, CMS will continue to exercise enforcement discretion to permit pathologists and other laboratory personnel to review laboratory digital data, digital results, and digital images (“digital materials”) remotely, without obtaining a separate CLIA certificate for the remote testing site, provided that the designated primary site or home base has such a certificate (using the address of the primary site) and the work being performed at the remote testing site falls within the specialties/subspecialties under the primary site’s certificate.”16
Multiple WSI systems have submitted 510(k) premarket notifications and gained marketing authorization. Per the FDA, “The whole slide imaging system is an automated digital slide creation, viewing, and management system intended as an aid to the pathologist to review and interpret digital images of surgical pathology slides prepared from formalin-fixed, paraffin-embedded (FFPE) tissue. The system generates digital images that would otherwise be appropriate for manual visualization by conventional brightfield microscopy. The whole slide imaging system is not intended for use with slides prepared from frozen tissue, cytology, and non-FFPE hematopathology specimens. The whole slide imaging system consists of an image management system, a scanner and associated software, and a display monitor. The whole slide imaging system does not include any automated Image Analysis Applications that would constitute computer aided detection or diagnosis. Pathologists view and interpret scanned digital images, employing appropriate processes to ensure the validity of the interpretation.”17
Currently, there is only one on-market artificial intelligence tool that has marketing authorization as a software algorithm device to assist users in digital pathology. According to the FDA, “A software algorithm device to assist users in digital pathology is an in vitro diagnostic device intended to evaluate acquired scanned pathology whole slide images. The device uses software algorithms to provide information to the user about presence, location, and characteristics of areas of the image with clinical implications. Information from this device is intended to assist the user in determining a pathology diagnosis.”18
Reimbursement of digital pathology is evolving. Currently, the standalone process of whole slide imaging is not reimbursed. However, there are a small number of existing Current Procedural Terminology (CPT) Category I codes for IHC/ISH using computer-assisted technology that implicitly include reimbursement for digitization of whole slide images as part of the quantitative image analysis process.19 These Category l tissue codes have not been revalued in a decade, leading to suboptimal reimbursement for biomarker image analysis. In addition, there currently are no Category l tissue codes for other AI image analysis applications such as H&E.
The College of American Pathologists and the American Medical Association have been making strides in creating 43 digital pathology CPT Category III add-on codes to help close this gap. The use of these codes will inform the Centers for Medicare & Medicaid Services when it is making reimbursement decisions for new services. Assuming that laboratories are diligent in consistently using them, which will establish an ongoing record that supports their value, the new codes could be seen as a step toward potential greater reimbursement in the future.
When digitized glass slides are used for consultations and second opinions, the appropriate Cat III add-on codes should be used.
Implementing digital pathology
As adoption of digital pathology gains momentum, the collective experience of early adopters provides a rich resource for institutions that are just beginning the planning process.20,21 Technical readiness, operational readiness, and cost are identified as the most significant challenges.21 A critical step in adopting digital pathology is to assemble a multidisciplinary implementation team to evaluate pathologists’ readiness for a transition to digital pathology, propose a budget, and evaluate resources needed for implementation, such as appropriate data storage and internet bandwidth.22
The initial assessment will lead to a better understanding of resources and infrastructure requirements than can then lead to a plan for execution, including definition of workflow, validation and delineation of SOPs, and training. To support labs in the implementation process, validation guidelines have been established to ensure whole slide digital images are acceptable for clinical diagnosis.23,24 Additionally, the National Society for Histotechnology has created an online Digital Pathology Certificate of Completion program to increase knowledge and improve competency in whole slide imaging.25
Given the complex, multifaceted nature of change management, it comes as no surprise that experts advocate a stepwise implementation, with the identification of one or two clinical needs as a starting point, adding additional applications over time.20
There are different perspectives to consider when implementing digital pathology. The first category encompasses tangible issues: acquisition costs of the digital pathology solution and personnel costs of planning and implementation, including validation, and new reimbursement strategies are just a few examples.22 The second category includes costs related to infrastructure updates and upgrades, notably in IT and training, personnel realignment with the new workflow, and the technical expertise and core competencies to support it.22 Last but not least is the human factor; change is difficult. As pathologists, lab personnel, IT, and other stakeholders learn new ways to work and collaborate, they develop the groundwork for a more efficient digital workflow.
References
- Zarella MD, Bowman D, Aeffner F, et al. A Practical Guide to Whole Slide Imaging: A White Paper from the Digital Pathology Association. Arch Pathol Lab Med. 2019;143(2):222-234. doi:10.5858/arpa.2018-0343-RA.
- Parwani AV. Digital pathology as a platform for primary diagnosis and augmentation via deep learning. Artificial Intelligence and Deep Learning in Pathology. Elsevier; 2021:93-118.
- Williams BJ, Bottoms D, Treanor D. Future-proofing pathology: the case for clinical adoption of digital pathology. J Clin Pathol. 2017;70(12):1010-1018. doi:10.1136/jclinpath-2017-204644.
- About digital pathology. DPA. Accessed February 21, 2024. https://digitalpathologyassociation.org/about-digital-pathology.
- Vodovnik A. Diagnostic time in digital pathology: A comparative study on 400 cases. J Pathol Inform. 2016;29;7:4. doi:10.4103/2153-3539.175377.
- Clarke E, Doherty D, Randell R, et al. Faster than light (microscopy): superiority of digital pathology over microscopy for assessment of immunohistochemistry. J Clin Pathol. 2023;76(5):333-338. doi:10.1136/jclinpath-2021-207961.
- Eloy C, Marques A, Pinto J, et al. Artificial intelligence-assisted cancer diagnosis improves the efficiency of pathologists in prostatic biopsies. Virchows Arch. 2023;482(3):595-604. doi:10.1007/s00428-023-03518-5.
- Herrmann MD, Clunie DA, Fedorov A, et al. Implementing the DICOM Standard for Digital Pathology. J Pathol Inform. 2018 Nov 2;9:37. doi: 10.4103/jpi.jpi_42_18.
- Guo H, Birsa J, Farahani N, et al. Digital pathology and anatomic pathology laboratory information system integration to support digital pathology sign-out. J Pathol Inform. 2016;4;7:23. doi:10.4103/2153-3539.181767.
- Casterá Redal C, Bernet Vegué L. "HER2 immunohistochemistry inter-observer reproducibility in 205 cases of invasive breast carcinoma additionally tested by ISH" Answer to the statistical issue to avoid misinterpretation. Ann Diagn Pathol. 2020;48:151566. doi:10.1016/j.anndiagpath.2020.151566.
- Brunnström H, Johansson A, Westbom-Fremer S, et al. PD-L1 immunohistochemistry in clinical diagnostics of lung cancer: inter-pathologist variability is higher than assay variability. Mod Pathol. 2017;30(10):1411-1421. doi:10.1038/modpathol.2017.59.
- Gough M, Liu C, Srinivasan B, et al. Improved concordance of challenging human epidermal growth factor receptor 2 dual in-situ hybridisation cases with the use of a digital image analysis algorithm in breast cancer. Histopathology. 2023;83(4):647-656. doi:10.1111/his.15000.
- Haragan A, Parashar P, Bury D, Cross G, Gosney JR. Machine-learning-based image analysis algorithms improve interpathologist concordance when scoring PD-L1 expression in non-small-cell lung cancer. J Clin Pathol. 2024;18;77(2):140-144. doi:10.1136/jcp-2023-208978.
- Regulations.Gov, Enforcement Policy for Remote Digital Pathology Devices During the Coronavirus Disease 2019 (COVID-19) Public Health Emergency Guidance for Industry, Clinical Laboratories, Healthcare Facilities, Pathologists, and Food and Drug Administration Staff. Accessed February 21, 2024. https://www.regulations.gov/document/FDA-2020-D-1138-0078.
- Withdrawn or expired guidance. U.S. Food and Drug Administration. Published December 18, 2023. Accessed February 21, 2024. https://www.fda.gov/medical-devices/guidance-documents-medical-devices-and-radiation-emitting-products/withdrawn-or-expired-guidance.
- CMS.gov. Accessed February 21, 2024. https://www.cms.gov/files/document/qso-23-15-clia.pdf.
- US Food and Drug Administration. Product classification. Accessed February 21, 2024. https://www.accessdata.fda.gov/scripts/cdrh/cfdocs/cfpcd/classification.cfm?id=5344.
- US Food and Drug Administration. Product classification. Accessed February 21, 2024. https://www.accessdata.fda.gov/scripts/cdrh/cfdocs/cfpcd/classification.cfm?id=5349
- American Medical Association. AMA CPT® licensing overview. American Medical Association. Published May 31, 2023. Accessed February 21, 2024. https://www.ama-assn.org/practice-management/cpt/ama-cpt-licensing-overview.
- Evans AJ, Salama ME, Henricks WH, Pantanowitz L. Implementation of Whole Slide Imaging for Clinical Purposes: Issues to Consider from the Perspective of Early Adopters. Arch Pathol Lab Med. 2017;141(7):944-959. doi:10.5858/arpa.2016-0074-OA.
- Hartman DJ, Pantanowitz L, McHugh JS, et al. Enterprise Implementation of Digital Pathology: Feasibility, Challenges, and Opportunities. J Digit Imaging. 2017;30(5):555-560. doi:10.1007/s10278-017-9946-9.
- Lujan G, Quigley JC, Hartman D, et al. Dissecting the Business Case for Adoption and Implementation of Digital Pathology: A White Paper from the Digital Pathology Association. J Pathol Inform. 2021;7;12:17. doi:10.4103/jpi.jpi_67_20.
- Evans AJ, Brown RW, Bui MM, et al. Validating Whole Slide Imaging Systems for Diagnostic Purposes in Pathology. Arch Pathol Lab Med. 2022;1;146(4):440-450. doi:10.5858/arpa.2020-0723-CP.
- Bui MM, Riben MW, Allison KH, et al. Quantitative Image Analysis of Human Epidermal Growth Factor Receptor 2 Immunohistochemistry for Breast Cancer: Guideline from the College of American Pathologists. Arch Pathol Lab Med. 2019;143(10):1180-1195. doi:10.5858/arpa.2018-0378-CP.
- Digital pathology certificate of completion program. Nsh.org. Accessed February 21, 2024. https://elearn.nsh.org/products/digital-pathology-certificate-of-completion-program.
To take the April CE test online go HERE. For more information, visit the Continuing Education tab.
About the Author

Carolyn Pressman, PhD
PhD
Scientific Partner, Medical and Scientific Affairs, Roche Diagnostics, received her doctoral degree in Genes and Development from the University of Texas Health Science Center, at Houston. Her current work as part of the medical and scientific affairs team focuses on digital pathology and AI image analysis.